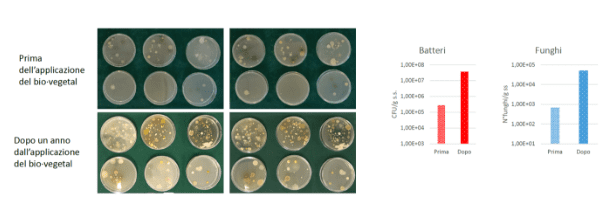
bio vegetal 1

Una recente ricerca sperimentale pluriennale conferma i numerosi benefici di Bio Vegetal (l’unico biofertilizzante con ricca sostanza organica e oltre 200 tipi di microrganismi). Gli studi, guidati dal ricercatore Luigi Tarricone del CREA-VE, in collaborazione con enti accreditati e il team “Ricerca e sviluppo” di Tersan Puglia, ha esaminato gli effetti dell’utilizzo di Bio Vegetal sui vitigni Chardonnay e Nero di Troia.
La ricerca ha evidenziato vantaggi significativi derivanti dall’uso di Bio Vegetal, tra cui:Â
- Miglioramento del microbiota del suolo e incremento della biodiversità : l’aumento della presenza di funghi e batteri favorisce un ambiente più stabile e resiliente che contribuisce a migliorare la salute del terreno e delle piante.
- Miglioramento qualitativo e quantitativo delle produzioni: le piante trattate hanno mostrato una migliore crescita vegetativa, con raccolti più abbondanti (+30%) e di qualità .

- Sostenibilità ambientale: l’uso di Bio Vegetal ha migliorato la capacità del suolo di trattenere l’acqua, aiutando le colture a resistere meglio alla siccità e ai cambiamenti climatici.
- Incremento del carbonio stoccato nei suoli: un suolo ricco di microrganismi può sequestrare più carbonio, contribuendo alla mitigazione dei cambiamenti climatici.
I risultati di questa ricerca sperimentale confermano che Bio Vegetal è un alleato indispensabile per i viticoltori che desiderano migliorare la salute del suolo, aumentare la produttività e proteggere l’ambiente.Â
Grazie a queste evidenze scientifiche, Bio Vegetal si conferma una soluzione efficace e sostenibile per un’agricoltura rigenerativa e rispettosa del nostro pianeta.
Vieni a conoscere tutti i vantaggi alla Grape Exhibition 2024, una giornata tecnica in campo che si svolgerà il 20 giugno, alle ore 15:00, presso Cantine Polvanera, a Gioia del Colle (BA).Â
Iscriviti qui: https://bit.ly/45h5iNLÂ
Comunicato a cura di: Bio Vegetal
© fruitjournal.com